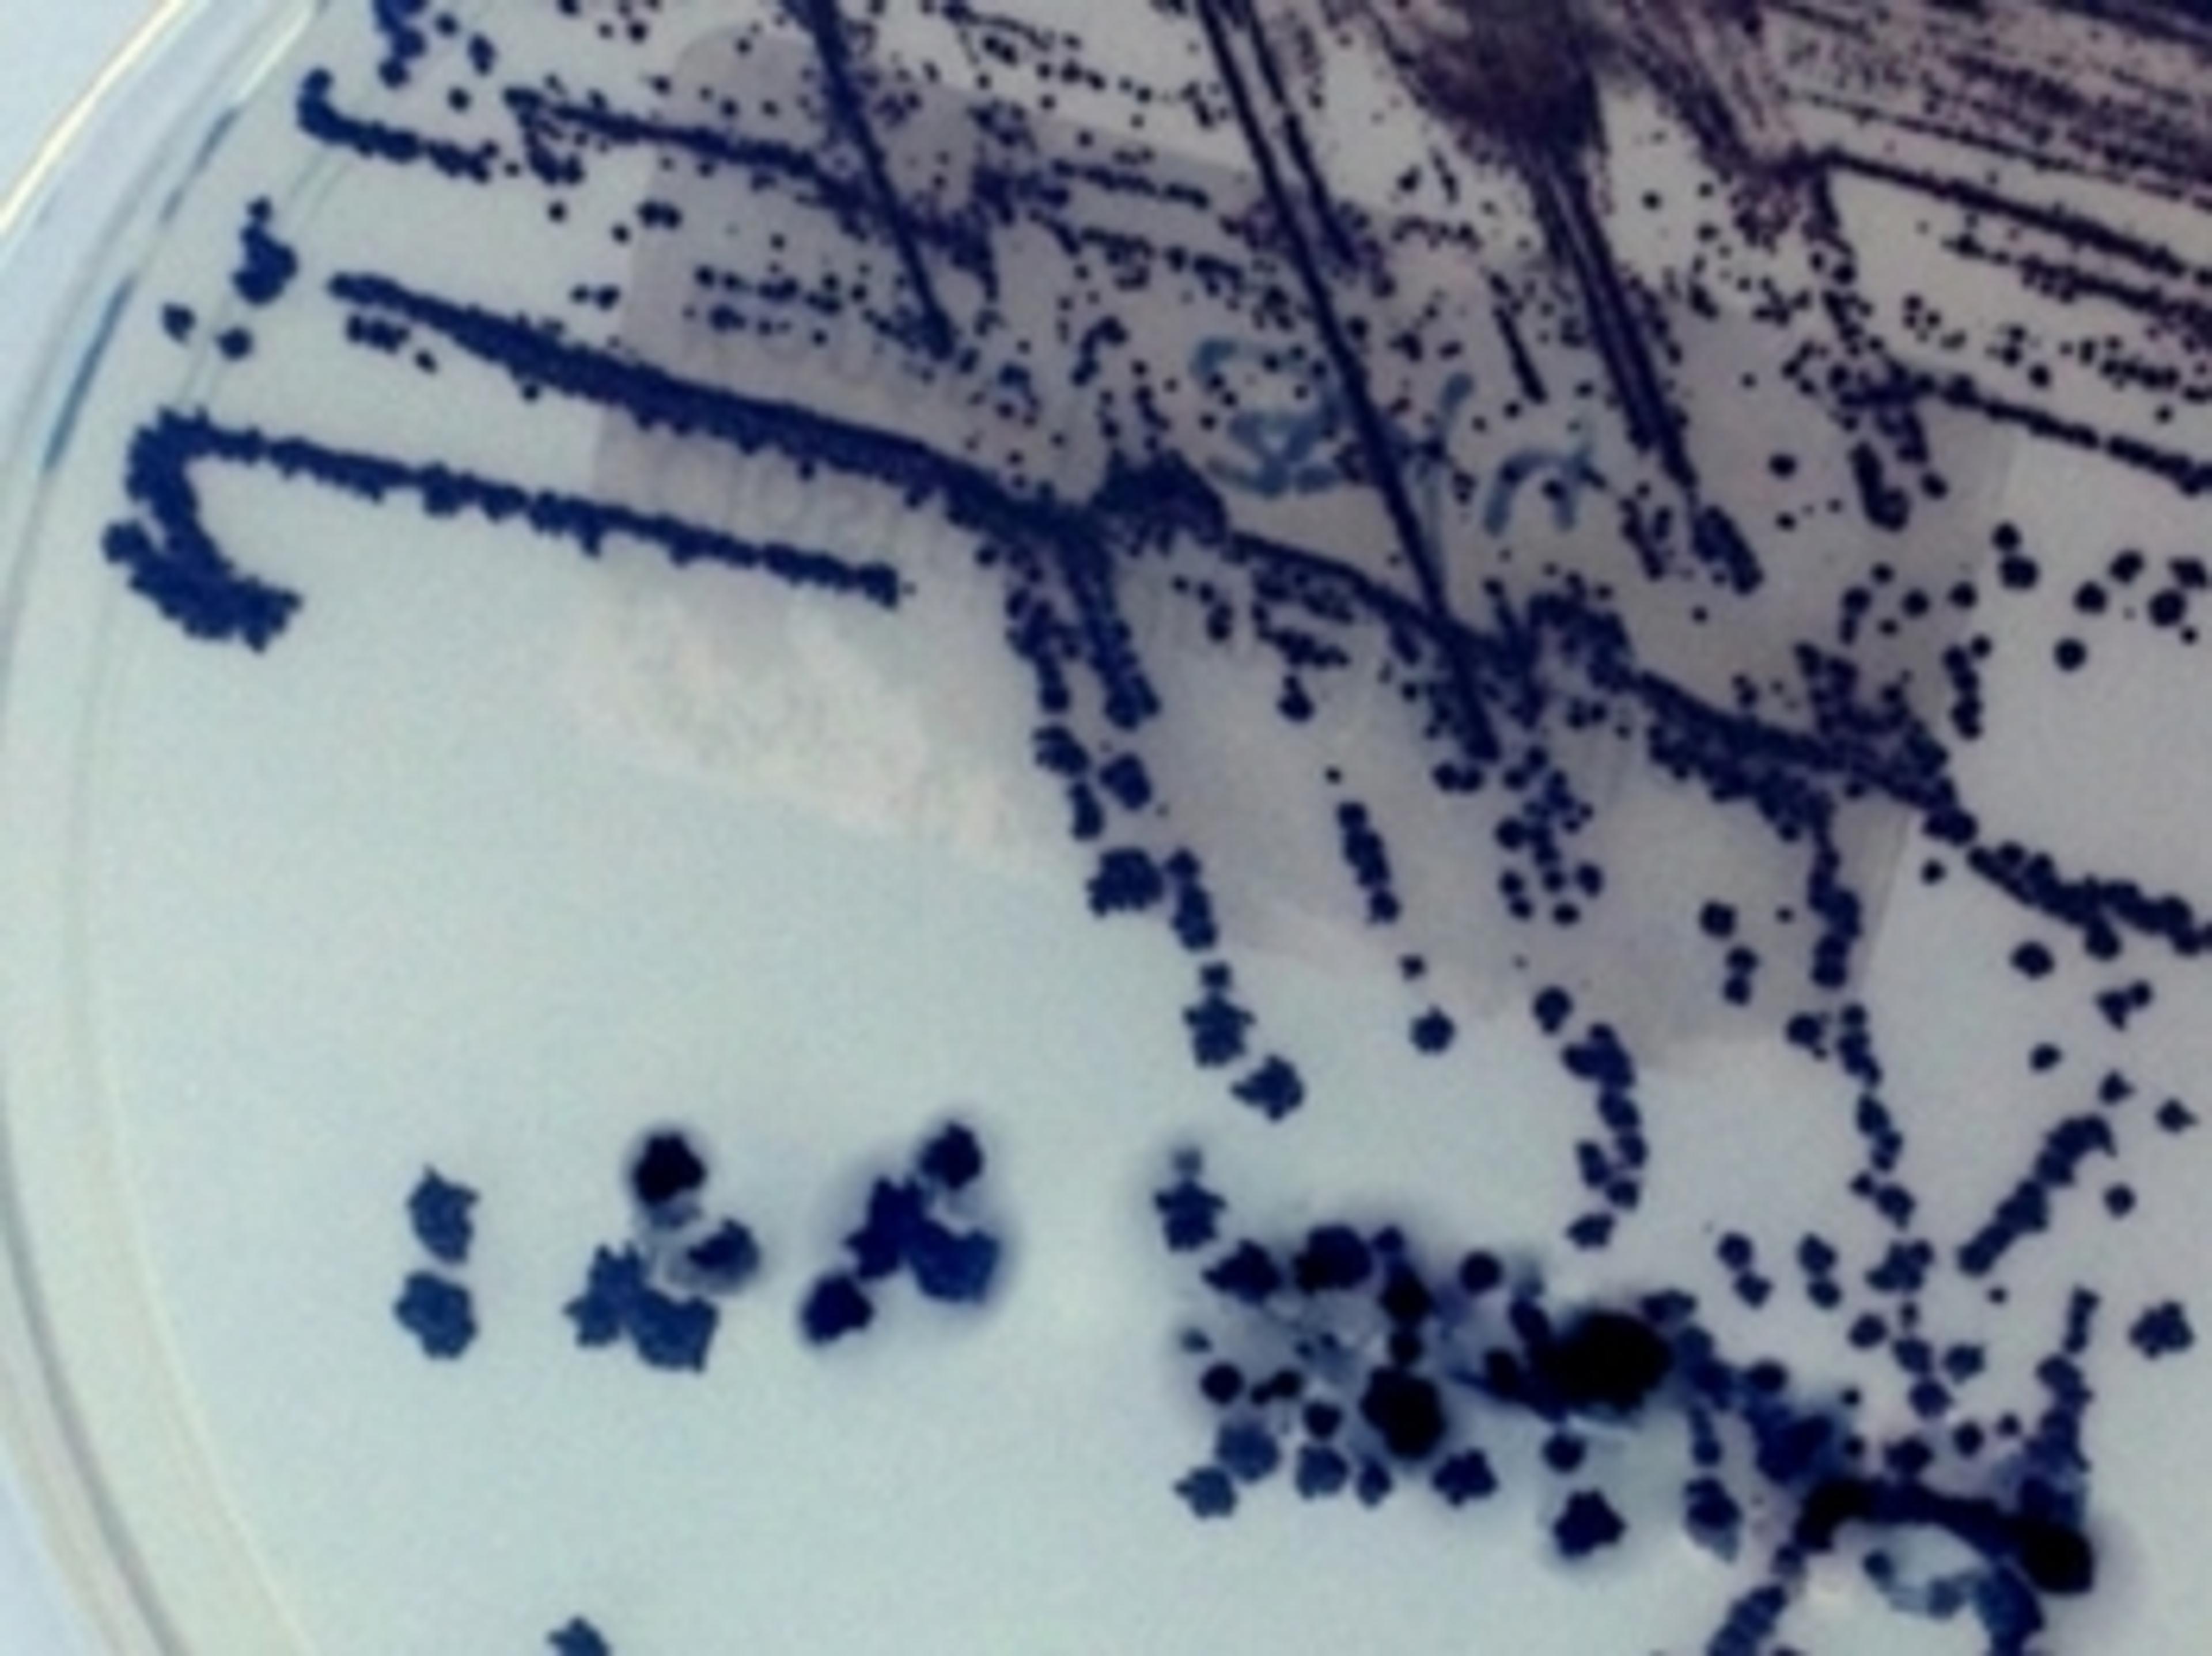

Multiplex Assay Technology Enables In-Depth Insights into Pneumonia Infections
Prof. Dr. Ger Rijkers tells SelectScience how he is using Luminex xMAP Technology® to develop a multiplex assay that can identify specific antibodies to multiple serotypes of S. pneumoniae in a single test